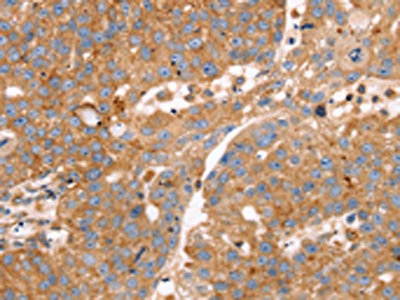

SLC25A38 Antibody
-
中文名稱:SLC25A38兔多克隆抗體
-
貨號(hào):CSB-PA091535
-
規(guī)格:¥1100
-
圖片:
-
The image on the left is immunohistochemistry of paraffin-embedded Human liver cancer tissue using CSB-PA091535(SLC25A38 Antibody) at dilution 1/25, on the right is treated with synthetic peptide. (Original magnification: ×200)
-
The image on the left is immunohistochemistry of paraffin-embedded Human breast cancer tissue using CSB-PA091535(SLC25A38 Antibody) at dilution 1/25, on the right is treated with synthetic peptide. (Original magnification: ×200)
-
-
其他:
產(chǎn)品詳情
-
Uniprot No.:
-
基因名:SLC25A38
-
別名:SLC25A38; Mitochondrial glycine transporter; Mitochondrial glycine transporter GlyC; Solute carrier family 25 member 38
-
宿主:Rabbit
-
反應(yīng)種屬:Human
-
免疫原:Synthetic peptide of Human SLC25A38
-
免疫原種屬:Homo sapiens (Human)
-
標(biāo)記方式:Non-conjugated
-
抗體亞型:IgG
-
純化方式:Antigen affinity purification
-
濃度:It differs from different batches. Please contact us to confirm it.
-
保存緩沖液:-20°C, pH7.4 PBS, 0.05% NaN3, 40% Glycerol
-
產(chǎn)品提供形式:Liquid
-
應(yīng)用范圍:ELISA,IHC
-
推薦稀釋比:
Application Recommended Dilution ELISA 1:2000-1:5000 IHC 1:25-1:100 -
Protocols:
-
儲(chǔ)存條件:Upon receipt, store at -20°C or -80°C. Avoid repeated freeze.
-
貨期:Basically, we can dispatch the products out in 1-3 working days after receiving your orders. Delivery time maybe differs from different purchasing way or location, please kindly consult your local distributors for specific delivery time.
-
用途:For Research Use Only. Not for use in diagnostic or therapeutic procedures.
相關(guān)產(chǎn)品
靶點(diǎn)詳情
-
功能:Mitochondrial glycine transporter that imports glycine into the mitochondrial matrix. Plays an important role in providing glycine for the first enzymatic step in heme biosynthesis, the condensation of glycine with succinyl-CoA to produce 5-aminolevulinate (ALA) in the mitochondrial matrix. Required during erythropoiesis.
-
基因功能參考文獻(xiàn):
- report confirms the considerable variability in manifestations among patients with ALAS2 or SLC25A38 mutations and draws attention to differences in the assessment and the monitoring of iron overload and its complications PMID: 28772256
- the biochemical and molecular characterization of yeast Hem25p and human SLC25A38, providing evidence that they are mitochondrial carriers for glycine. In particular, the hem25Delta mutant manifests a defect in the biosynthesis of delta-aminolevulinic acid and displays reduced levels of downstream heme and mitochondrial cytochromes. PMID: 27476175
- Appoptosin can interact with mitochondrial outer-membrane fusion proteins and regulates mitochondrial morphology. PMID: 26813789
- Given the tolerability of glycine and folate in humans, this study points to a potential novel treatment for SLC25A38 congenital sideroblastic anemia PMID: 26821380
- This study findings reveal a novel role for appoptosin in neurological disorders with tau neuropathology, linking caspase-3-mediated tau cleavage to synaptic dysfunction and behavioral/motor defects. PMID: 26335643
- Letter/Case Report: novel frameshift mutation in SLC25A38 causing congenital sideroblastic anaemia. PMID: 25512395
- Several missense mutations are found in SLC25A38 in a Chinese population with congenital sideroblastic anemia. PMID: 24323989
- Our study identifies appoptosin as a crucial player in apoptosis and a novel pro-apoptotic protein involved in neuronal cell death. PMID: 23115192
- Compares and contrasts all the known human SLC25A* genes and includes functional information. PMID: 23266187
- Mutations in the SLC25A38 gene cause severe, non-syndromic, microcytic/hypochromic sideroblastic anemia in many populations. PMID: 21393332
- Twelve CSA probands had biallelic mutations in SLC25A38 PMID: 19731322
顯示更多
收起更多
-
相關(guān)疾?。?/div>Anemia, sideroblastic, 2, pyridoxine-refractory (SIDBA2)亞細(xì)胞定位:Mitochondrion inner membrane; Multi-pass membrane protein.蛋白家族:Mitochondrial carrier (TC 2.A.29) family, SLC25A38 subfamily組織特異性:Preferentially expressed in erythroid cells.數(shù)據(jù)庫(kù)鏈接:
Most popular with customers
-
-
YWHAB Recombinant Monoclonal Antibody
Applications: ELISA, WB, IHC, IF, FC
Species Reactivity: Human, Mouse, Rat
-
Phospho-YAP1 (S127) Recombinant Monoclonal Antibody
Applications: ELISA, WB, IHC
Species Reactivity: Human
-
-
-
-
-